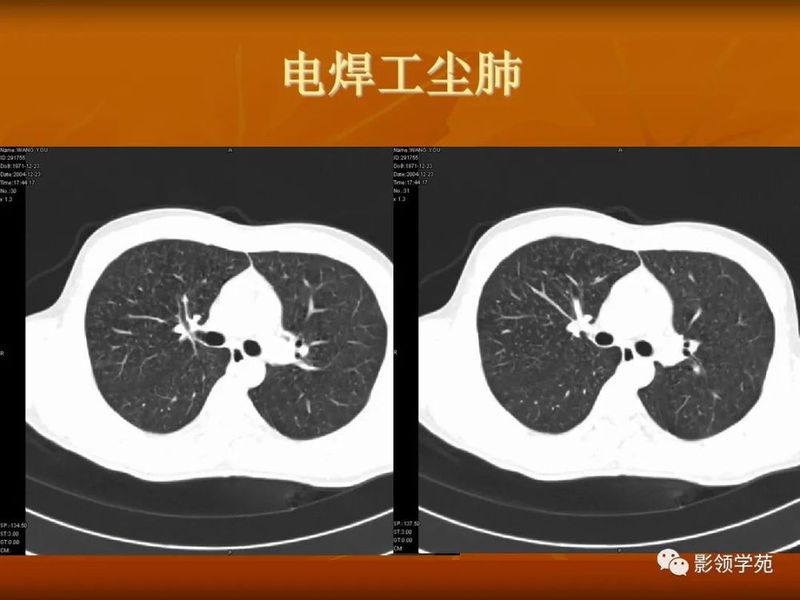
图片

肺结核的渗出性改变:片状、边界模糊

有硬化部分的磨玻璃样变

过敏性肺炎

马赛克征

肺出血(片状、边缘模糊)

(1)较大含空洞性肿块,洞壁较厚,大于15mm,空洞外壁有分叶、毛刺,洞壁凹凸不平有壁结节,增强可见不规则强化,周围未见明显卫星病灶时,首先考虑周围型肺癌;癌性空洞洞壁一般肺门侧较厚,空洞多偏于外侧,伴有同侧淋巴结肿大更支持肺癌诊断。
(2)空洞病变发生于双肺上叶尖后段、下叶背段,病变周围可见点状、结节状及片状卫星病灶,洞壁组织无明显强化或有包膜线样强化时,考虑结核;结核球的空洞多位于病变的肺门侧,与引流支气管相同,洞内壁一般较光滑。


(5)肺内多发结节,由肉芽肿和炎症构成,较大结节发生空洞,多数结节边缘见有血管进入,则要考虑到肺韦格氏肉芽肿可能。

























熟悉掌握肺部基本病变的CT表现,是诊断肺部疾病的基础,要仔细观察CT片上所呈现的各种表现,发现其特点,并对这种CT特点与病理表现的相互联系有清楚的理解,以便准确解释CT检查所包含全部信息和细微差别,要特别注意是相同疾病,不同表现,不同疾病,相同表现,要求我们必须密切结合临床症状及各种实验室检查指标,对每一个CT特征进行仔细的分析与鉴别,做出较为准确的诊断结果。
编辑:Yan